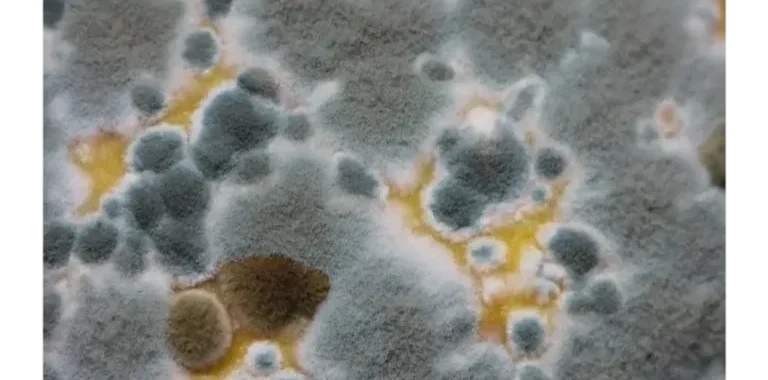

SmartChoice Heating, Cooling and Home Improvements
Expert drain cleaning services in Tucson are available at Smartchoicetucson.com. Clogged
Skin Camouflage
Get precise vitiligo patch blending treatment at Skincamouflage.ae, offering specialized solutions
Modern Deals Pvt Ltd
Upgrade your driving experience with practical Car Accessories Online designed for